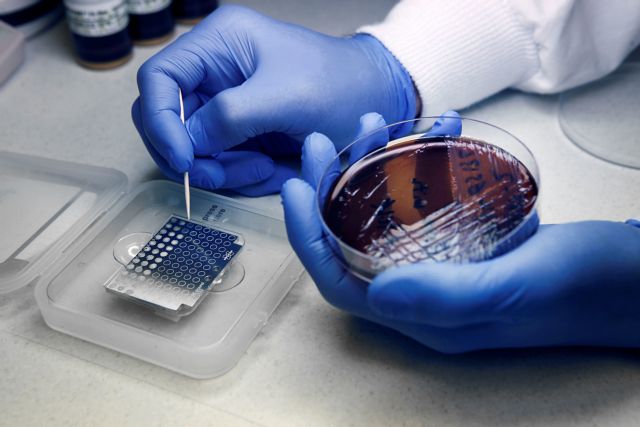

Κλιμάκια του ΕΟΔΥ αποτελούμενα και από Κινητές Ομάδες Υγείας (ΚΟΜΥ) πραγματοποιούν δωρεάν ελέγχους ταχείας ανίχνευσης αντιγόνου (rapid test), μέσα από το αυτοκίνητο (drive through) στις ακόλουθες περιοχές της χώρας:
– ΠΕ Χίου: Ιωνικό Κολυμβητήριο, 10:00-14:00
– ΠΕ Πέλλας: Κρύα Βρύση, 10:00-14:00
– ΠΕ Βορείου Τομέα Αθηνών: Δ. Αγ. Παρασκευής, Σπάρτης 1 Γήπεδο Σπυρούδη (Αθλητικό Κέντρο Σταύρος Κότσης), 10:00-15:00
– ΠΕ Δυτικού Τομέα Αθηνών: Θέατρο Πέτρας, 10:00-15:00
– ΠΕ Αιτωλοακαρνανίας: Δάφνη Ναυπάκτου, 12:00-15:00
– ΠΕ Αιτωλοακαρνανίας: Παπαδιαμαντοπούλου 56, Μεσολόγγι, 12:00-15:00
– ΠΕ Φθιώτιδας: Ομβριακή, 09:00-14:00
– ΠΕ Φθιώτιδας: Νέο Μοναστήρι, 09:00-13:00
– ΠΕ Φθιώτιδας: Δομοκός, 09:00-13:00
– ΠΕ Μαγνησίας: Πανθεσσαλικό Στάδιο Βόλου, 09:00-14:00
– ΠΕ Ευβοίας: Βουλγαροκτόνου 36, Ψαχνά, 09:00-14:00
– ΠΕ Θεσσαλονίκης: Ποσειδώνιο, 10:00-14:00
– ΠΕ Θεσσαλονίκης: Καυτανζόγλειο, 10:00-14:00